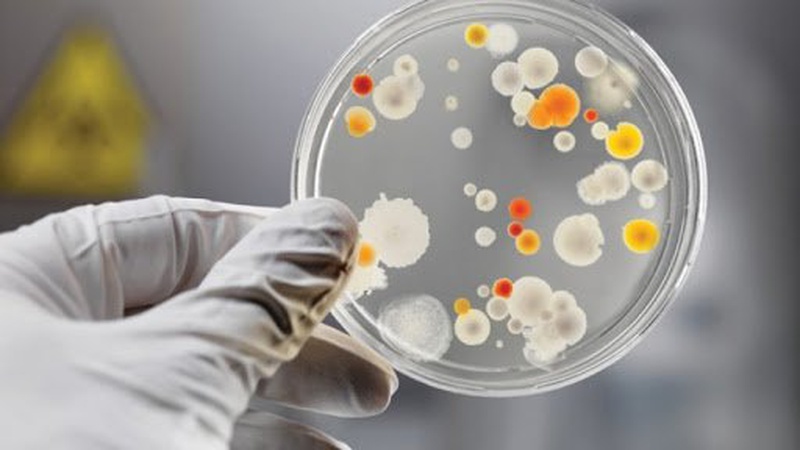
Лептоспіроз: що це та як уникнути

Лептоспіроз – небезпечна зооантропонозна (спільна для тварин та людей) інфекційна хвороба, спричинена збудником – бактерією Leptospira. Характеризується ураженням печінки, нирок, нервової системи та супроводжується загальною інтоксикацією, гарячкою, жовтяницею, геморагічним синдромом і нирковою недостатністю.
Про це йдеться на сайті Волинського обласного центру контролю та профілактики хвороб МОЗ України.
У ВООЗ вважають лептоспіроз – найпоширенішим зооантропонозним захворюванням у світі: щороку реєструється понад 1 млн. випадків хвороби та до 60 тис. людей помирає.
В Україні захворюваність на лептоспіроз сезонна, ризик зараження зростає влітку, коли люди більше часу проводять біля водойм.
Ця недуга залишається однією з найбільш розповсюджених природно-осередкових інфекційних хвороб в нашій країні та є значимою, в соціально-економічному аспекті, інфекційну хворобу, що призводить до ускладнень з високою летальністю.
Основними джерелами збудників цієї інфекції є тварини – дрібні ссавці (гризуни і комахоїди), дикі та сільськогосподарські тварини, домашні – собаки, кішки, промислові тварини (лисиці, нутрії). Зараження від хворої людини практично не спостерігається. Інфікування відбувається при вживанні сирої води з відкритих водоймищ, під час купання, при роботі на заводнених територіях без спецодягу, вживанні харчових продуктів, до яких мали доступ гризуни, контакт з хворими тваринами та інше.
Інкубаційний період захворювання триває від двох днів до чотирьох тижнів. Симптоми варіюються від легких (головний біль, гарячка, біль у м’язах, почервоніння очей, діарея, висипання) до серйозних (ураження нирок, ураження печінки, менінгіт) і навіть смерті.
Природні умови Волині сприятливі для формування природно-осередкових інфекцій, тому завжди залишаються ризики їх виникнення, про що свідчать близько 70 ензоотичних територій по лептоспірозу. Така ситуація підтверджується високим відсотком інфікування збудниками дрібних ссавців – у понад 20% всіх досліджень, котрі проводяться під час епізоотичного моніторингу об’єктів довкілля, лабораторією особливо-небезпечних інфекцій ДУ «Волинський обласний центр контролю та профілактики хвороб МОЗ України».
Протягом останніх трьох років захворюваність лептоспірозом в області носить спорадичний характер. За період 2018-2020 років зареєстровано 7 випадків захворювання у мешканців Ковельського, Луцького, Володимир-Волинського, Рожищенського районів та м. Луцька. Всі випадки захворювання підтвердженні лабораторно. Умовами, що сприяли зараженню є ведення домашнього господарства, догляд за сільськогосподарськими тваринами без засобів захисту та купання у місцевих відкритих водоймах.
Лікарі-епідеміологи щорічно рекомендують проводити дератизаційні заходи на епідеміологічно значимих об’єктах (об’єкти харчування, комунальні, дитячі тощо), оптимальною є одномоментна суцільна дератизація, яка повинна проводитися двічі на рік (весною та восени).
Враховуючи вищенаведене, важливо пам’ятати, що для попередження небезпечної хвороби необхідно:
– купатися в спеціально відведених місцях. Зараження лептоспірозом частіше відбувається в закритих стоячих водоймищах, особливо мілководних. Слід пам’ятати, що ризик зараження зростає під час купання при наявності на тілі подряпин, ран та ковтанні води;
– бажано відмовитись від прогулянок босоніж у заболочених місцях;
– при виконанні польових робіт, риболовлі, полюванні, догляді за хворою худобою необхідно використовувати засоби індивідуального захисту – вдягати гумові чоботи, рукавички;
– не вживати в їжу м’ясо і молоко хворих на лептоспіроз тварин, сиру воду з відкритих водоймищ, не використовувати її для миття овочів, фруктів;
– забезпечити відповідний захист від гризунів місць проживання людей та особливо джерел водопостачання.
Якщо зараженню запобігти не вдалось та з’явилися симптоми хвороби (слабкість, підвищення температури тіла, біль у литкових м’язах, жовтяниця шкіри, крововиливи в сітківку ока тощо), негайно звертайтесь за медичною допомогою. Раннє звернення – сприяє швидкому одужанню без важких ускладнень.
Наступний допис
Коментарі